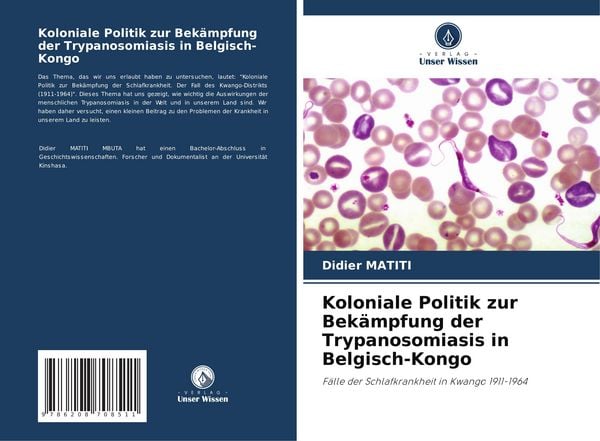
Koloniale Politik zur Bekämpfung der Trypanosomiasis in Belgisch-Kongo, Taschenbuch von Didier Matiti, Verlag Unser Wissen, 9786208708511

Tischplatte 160x30x4 cm Rechteckig Massivholz Akazie
€137.26
inkl. MwSt. zzgl. Versand
Versand: €0.00

Leuchtender Löwenkopf – Handyhülle Kompatibel mit iPhone 15
€29.95
inkl. MwSt. zzgl. Versand
Versand: €0.00

Vlies Fototapete - The beauty of nature: Waterfall 350x256 cm Landschaften c-A-0026-a-a
€142.78
inkl. MwSt. zzgl. Versand
Versand: €4.99

Bench Hipster 4 -teilig royalblau, grau-meliert, rot, schwarz Größe M
€27.20
inkl. MwSt. zzgl. Versand
Versand: €0.00

Die Götter aus dem All, Gebundene Ausgabe von Boguslaw Polch,Arnold Mostowicz,Alfred Gorny, SR Verlag, 978-3-947800-36-0
€40.00
inkl. MwSt. zzgl. Versand
Versand: €0.00

Fiat Panda Typ 312/319 Bj ab 2011 kompatible Schonbezüge in Schwarz/Beige D107
€119.00
inkl. MwSt. zzgl. Versand
Versand: €0.00

heine Átmeneti dzseki Női szürke , Méret 44
HUF 50,730.00
inkl. MwSt. zzgl. Versand

Werde, die Du bist - Hedwig Dohm (Buch)
€18.00
inkl. MwSt. zzgl. Versand
Versand: €0.00

Bild auf Leinwand - Leinwandbild - 3 Teile - Bahn Herbst So - 105x70cm - Wand Bild - Wanddeko - Wandbilder - Leinwanddruck - Bilder - Wanddekoratio...
€55.99
inkl. MwSt. zzgl. Versand
Versand: €12.99

Kompatibles Set 4x Toner für HP Color LaserJet Enterprise CP5525 CP5525DN CP5525N CP5525XH M750 M750dn M750n M750xh HP 650A von ABC
€250.77
inkl. MwSt. zzgl. Versand

Superfit Flavia C Winterschuhe Kinder (Gr 34 |braun |wasserdicht)
€99.95
inkl. MwSt. zzgl. Versand
Versand: €3.45

faina Blúz Női fekete , Méret S
HUF 68,040.00
inkl. MwSt. zzgl. Versand

Royal Shopper, Tasche 360° Mole 8, Tragkraft 50 kg, Volumen 41 L, Aluminium, Kugellagerräder, 29 cm Durchmesser, Wasserabweisend
€324.95
inkl. MwSt. zzgl. Versand

Kartridż z tonerem Katun Magenta, zamiennik MX61GTMA, 50247
€115.40
inkl. MwSt. zzgl. Versand
Versand: €0.00

Zier Schutzleiste Tür vorne rechts DIEDERICHS 4085420 für CITROËN
€20.74
inkl. MwSt. zzgl. Versand
Versand: €0.00

Tod auf St Michael's Mount - Angela Richford, Audio, 9783757018375
€10.19
inkl. MwSt. zzgl. Versand
Versand: €0.00

Maison Exclusive - Bücherregal 4 Fächer Grau 40x30x140 cm Holzwerkstoff
€63.95
inkl. MwSt. zzgl. Versand
Versand: €0.00

10 Papier Tütchen Streifen Weiß und Grau gestreift 11x20cm
€4.29(€429.00 / ct)
inkl. MwSt. zzgl. Versand
Versand: €4.95

Duschwannenträger passend für Hüppe EasyFlat 160 × 100 × 3 cm
€217.97
inkl. MwSt. zzgl. Versand
Versand: €0.00

vidaXL 7-tlg. Garten-Sofagarnitur mit Kissen Braun Poly Rattan Akazie
€589.32
inkl. MwSt. zzgl. Versand
Versand: €0.00

Kiwistar - Autoaufkleber - Baden-Württemberger Stolz - Neonorange - 50x25cm - Aufkleber für Auto, Laptop, Fahrrad, LKW, Motorrad mehrfarbig JDM D...
€18.99
inkl. MwSt. zzgl. Versand
Versand: €1.00

Urban Factory UPB22UF, 20000 mAh
€53.45
inkl. MwSt. zzgl. Versand
Versand: €0.00

Don't Make Me Raise Karen Voice Girly Tee - XX-Large - Black
€27.34
inkl. MwSt. zzgl. Versand
Versand: €0.00

Poster Sushi - Maguro Nigiri Standard / 30 cm x 30 cm
€15.90
inkl. MwSt. zzgl. Versand

Blume - Linien Punkte Wandtattoo in 6 Größen - Wandaufkleber Wall Sticker - Dekoration, Küche, Wohnzimmer, Schlafzimmer, Badezimmer
€17.99
inkl. MwSt. zzgl. Versand
Versand: €6.90
TECTAKE Drehbarer Armlehnstuhl Lenia, gepolstert 6er SetSamtoptik creme/schwarz
€445.99(€74,331.67 / ct)
inkl. MwSt. zzgl. Versand
Versand: €0.00

MuchoWow Wandteppich Wandbehang Weg im Nebel - Gemälde von Claude Monet 120x90 cm Tapisserie Dekoration Wandtuch - Wohnen - Aufhänger für die ...
€64.95
inkl. MwSt. zzgl. Versand
Versand: €0.00

FA1 143-935 Halter, Abgasanlage OE 2204920044 kompatibel mit S-Klasse
€7.00
inkl. MwSt. zzgl. Versand
Versand: €10.00

4er Set Tischset Uni "Haze" - Rutschfest - Kunststoff -Untersetzer - Platzdeckchen - Platzsets - Beige/Braun - 30x45cm
€22.95
inkl. MwSt. zzgl. Versand
Versand: €0.00

DeinDesign Slim Hülle für Samsung Galaxy S25 Silikon Case Ultra Dünn Handyhülle 1. FC Köln Aufstieg Offizielles Lizenzprodukt
€21.95
inkl. MwSt. zzgl. Versand
Versand: €3.95

Smart Case Holster passend für IPHONE 14 schwarz
€13.90
inkl. MwSt. zzgl. Versand
Versand: €0.00
MÄSER Suppenteller 21,6 cm, 6-er Set, Lumaca, LAGUNA
€24.99(€4,165.00 / ct)
inkl. MwSt. zzgl. Versand
Versand: €6.99

OGRO CORE FS8100/6501/6612 Dorma FS-Türdrücker-Rosetten-Garnitur
€75.57
inkl. MwSt. zzgl. Versand

ALTDECOR Polsterbett mit Bettkasten - EMMI - 200x200 Schwarz Casablanca - Bett mit Matratze H3/H4, Kopfteil, Boxbett, Doppelbett mit Stauraum
€1,359.90
inkl. MwSt. zzgl. Versand
Versand: €0.00

Beistelltisch Holz Beige Modern Elegant
€749.00
inkl. MwSt. zzgl. Versand
Versand: €0.00

Ganter Komfort Schnürschuhe Damen 31383733363537 Silber 39 EU
€167.16
inkl. MwSt. zzgl. Versand
Versand: €0.00

50 cm SWS Forst Schwert mit 2 Halbmeißel Sägeketten .325 1,5mm 78TG passend Husqvarna 550XP
€50.90
inkl. MwSt. zzgl. Versand
Versand: €4.90

Name It Vian Jogginghose Jungen
€12.95
inkl. MwSt. zzgl. Versand
Versand: €7.95

Doctor Eckstein Ultimate Supreme Night Cream 50ml
€109.00(€2,180,000.00 / l)
inkl. MwSt. zzgl. Versand

Skibox JUXT400 + Alu Relingträger CRV120NERO kompatibel mit Chevrolet Matiz II 05-09
€450.00
inkl. MwSt. zzgl. Versand
Versand: €0.00

MARCO TOZZI Damen Stiefel Western Cowboy Boot mit Zierriemen 2-25503-43, Größe:40 EU, Farbe:Grau
€57.99
inkl. MwSt. zzgl. Versand
Versand: €0.00

ABAKUHAUS Leopard-Druck Bettlaken, Haut-Muster einer wilden afrikanischen Safari Tier leistungsstarke Panthera große Katze, weiches bequemes obere...
€26.99
inkl. MwSt. zzgl. Versand
Versand: €0.00

NRF 53805 Motorkühler OE C2C1448 kompatibel mit S-Type, XF, XJ
€318.00
inkl. MwSt. zzgl. Versand
Versand: €0.00

Kovvar Gummi Kofferraummatte für Volvo V40 2012-2019 - Nur passend für Modelle mit tiefem Ladeboden (exkl. D2/D3/D4 Euro6) - Duogrip
€49.95
inkl. MwSt. zzgl. Versand
Versand: €4.99

Honda CR-V Petrol & Diesel (02 - 06) Haynes Repair Manual
€30.27
inkl. MwSt. zzgl. Versand
Versand: €3.89

FoodSaver VS3190X Vakuumierer Schwarz, Edelstahl
€175.68
inkl. MwSt. zzgl. Versand
Versand: €6.99

Dehn MMVK 6.8 FRM10X35 V2A MMV-Klemme für Rd 6-8mm mit Flachrundschraube, NIRO (390259)
€9.64
inkl. MwSt. zzgl. Versand
Versand: €4.95

MuchoWow Glasbilder - Bilder auf Wandbild - Foto auf Glas Abstrakt - Schwarz - Farbe - Modern 30x30 cm Wanddekoration aus Glas - Acrylglasbild - Ac...
€29.99
inkl. MwSt. zzgl. Versand
Versand: €0.00

MuchoWow Mauspad Mousepad Dampfzug inmitten der grünen Landschaft Schottlands 40x40 cm - Mousepads - Maus Mat - Pad - Mausunterlage - Schreibtis...
€23.99
inkl. MwSt. zzgl. Versand
Versand: €0.00

Panzerglass Displayschutz Case Friendly iPhone 6/6S/7/8/SE 2020/2022 - Panzerglass
CHF 23.99
inkl. MwSt. zzgl. Versand

Blumen & Pflanzen 2025 Fotokalender DIN A5
€18.90
inkl. MwSt. zzgl. Versand
Versand: €0.00

Poster 30x20 cm "Mediterrane Fliese" artboxONE - Abstrakt,Geometrie
€14.99
inkl. MwSt. zzgl. Versand
Versand: €4.99

Leuchtbild Acrylglas ️ Leuchtturm bei stürmischer See | Canvalight DIA Schmal 80 x 200 / warmweiß bis kaltweiß
€1,409.00
inkl. MwSt. zzgl. Versand

Stile Benetton Stoffhose creme Gr. 36 Damen
€21.34
inkl. MwSt. zzgl. Versand
Versand: €0.00

Leinwand Buchstabe Q - Sans Serif schwarz/weiß / 20 cm x 30 cm
€29.90
inkl. MwSt. zzgl. Versand

Alu-Dibond "Colorful Grand Palace" 30x20 cm artboxONE
€59.99
inkl. MwSt. zzgl. Versand
Versand: €4.99

9 Pol Sub-D Kabel, vergossen, Länge: 3.0 m, Stecker-Stecker (11004122)
€6.80
inkl. MwSt. zzgl. Versand
Versand: €0.00

Poster mit Rahmen schwarz "Sydney Map" artboxONE - Städte / Sydney,Kartografie
€54.99
inkl. MwSt. zzgl. Versand

Glasbild Hamburg Dockland 20x20 cm
€9.90
inkl. MwSt. zzgl. Versand
Versand: €5.70

CATU Elektriker Schutzhandschuhe, Größe 9 (Isolierhandschuhe Schutzhandschuhe)
€55.97
inkl. MwSt. zzgl. Versand
Versand: €4.90

Mexen Rox Duschabtrennung 2-flügelig verschiebbar 140 + 70 x 150 cm, transparent, gebürstetes Gun Grau - 8C9-140-070-66-00
€420.99
inkl. MwSt. zzgl. Versand
Versand: €79.99

Kraft&Dele KD1592 Polierschwamm konisch Set 3tlg
€5.00
inkl. MwSt. zzgl. Versand
Versand: €8.00

Herth+Buss Elparts Steckdose 51307070
€28.23
inkl. MwSt. zzgl. Versand

Lagerung Lenker für Querlenker für FIAT Scudo (270, 272) Hinten Vorne Links 411194 SPIDAN CHASSIS PARTS
€58.88
inkl. MwSt. zzgl. Versand
Versand: €0.00

Poster mit schwarzem Rahmen "Now Never" artboxONE - Typografie,Schwarzweiß,Männer
€24.99
inkl. MwSt. zzgl. Versand
Versand: €4.99

Time To Fold The Cards - The Forgotten Sons Of Ben Cartwright, CD
€14.99
inkl. MwSt. zzgl. Versand
Versand: €2.95
Koloniale Politik zur Bekämpfung der Trypanosomiasis in Belgisch-Kongo, Taschenbuch von Didier Matiti, Verlag Unser Wissen, 9786208708511
€43.90
inkl. MwSt. zzgl. Versand
Versand: €0.00

BOSCH Topfbürste Nylonborste mit Korund 50 mm 1 mm
€13.30
inkl. MwSt. zzgl. Versand
Versand: €5.95

Brax Damen Style SHAKIRA C USED LIGHT VINTAGE BLUE, denim hellblau, Gr. 48
€89.95
inkl. MwSt. zzgl. Versand

Mende Frames 1,4 mm Doppel-Passepartout in Standardgrößen 42x59,4 cm (29,7x42 cm) Kanarienvogel (209)
€17.00
inkl. MwSt. zzgl. Versand

Gardinenstangen Weiß / Schwarz, Metall 20 mm Ø Platon Elanto
€66.10
inkl. MwSt. zzgl. Versand
Versand: €0.00

Wanduhr Leinwand Bild Uhr Quarz 60x30 Menschenmenge mit Regenschirmen Nacht - schwarze Hände
€49.99
inkl. MwSt. zzgl. Versand
Versand: €0.00

1540 Ø 13,00 mm, 52,00 mm - Louis Belet - - VHM-Eckfräser
€187.54
inkl. MwSt. zzgl. Versand

Mende Frames Bilderrahmen H011 Braun 10 x 13 cm aus Holz Made in Germany
€6.10
inkl. MwSt. zzgl. Versand

VEGAZ TS-303 Endschalldämpfer für TOYOTA COROLLA (ZZE12, NDE12, ZDE12) Auspuff
€61.86
inkl. MwSt. zzgl. Versand
Versand: €0.00
300x Deckel, PP, klar, rund, 196mm
€70.79(€235.97 / ct)
inkl. MwSt. zzgl. Versand
Versand: €0.00

vidaXL Kopfteil Braun Eichen-Optik Holzwerkstoff
€76.33
inkl. MwSt. zzgl. Versand
Versand: €0.00

Under Armour T-Shirt M Bordeaux - Rot - Herren - Pre-Loved Designer Fashion - Under Armour Second Hand Designer Shop
€19.99
inkl. MwSt. zzgl. Versand
Versand: €6.99

Wanduhr - Quadrat - Glasuhr - Brücke See - 40x40cm - Schleichendes Uhrwerk - Lautlos - zum Aufhängen bereit - Dekoration Modern - Wanddekoration ...
€58.99
inkl. MwSt. zzgl. Versand
Versand: €12.99

Poster mit Rahmen kiefer "Vulture" artboxONE - Tiere,Schwarzweiß - Geier,Greifvigel,Tier,Schwarzweiß,Mönchsgeier,Hässlich,Animal,Bird,Blackandwhite
€54.99
inkl. MwSt. zzgl. Versand
Versand: €4.99

Zimilo Babynahrungszubereiter 4-in-1 Baby Dampfgarer und Mixer, Dampfgaren, Mischen, Auftauen und Erhitzen, für Babynahrung, 24 × 14 × 20 cm
€49.99
inkl. MwSt. zzgl. Versand
Versand: €0.00

Farbband - schwarz-rot- für HP 81 als Doppelspule Gr.51- Farbbandfabrik Original Farbband Farbbandfabrik
€7.69
inkl. MwSt. zzgl. Versand
Versand: €4.99

A.S. Création Lilly & Luis 77078-3 10,05m x 0,53m Rapport: 0
€32.63
inkl. MwSt. zzgl. Versand
Versand: €3.99

Kaiser Betonbau Wand- und Deckenkrümmer 30° für M32 Rohre, 2-teilig, 1 Stk.
€10.00
inkl. MwSt. zzgl. Versand
Versand: €0.00

Leuchtbild Acrylglas ️ Bronze Zen Buddha | Canvalight DIA Schmal 60 x 180 / warmweiß bis kaltweiß
€1,189.00
inkl. MwSt. zzgl. Versand

Segeltau Armband Muttertag 1x Silber Vorder- & Rückseite
€39.00
inkl. MwSt. zzgl. Versand

Triton RAB-MS-X21-X1 Kunststoffbügel 60x30mm, schwarz
€8.12
inkl. MwSt. zzgl. Versand
Versand: €0.00

Richard Wagner
€12.00
inkl. MwSt. zzgl. Versand
Versand: €0.89

Drehtürenschrank >Dillingen< in VIKING OAK NACHBILDUNG - 270x208x58cm (BxHxT)
€629.95
inkl. MwSt. zzgl. Versand
Versand: €0.00

FC-Moto Hawk EVO-X Helm, schwarz matt/grün/weiß, XL
€125.49
inkl. MwSt. zzgl. Versand
Versand: €4.90

Leinwandbild ️ LIKE - Florales Porträt | Schmal | BigBilder 80 x 240 / Stärke 4 cm
€439.00
inkl. MwSt. zzgl. Versand

Kartsport fahren Evolution Wandtattoo Wandaufkleber Wall Sticker - Dekoration, Küche, Wohnzimmer, Schlafzimmer, Badezimmer
€34.90
inkl. MwSt. zzgl. Versand
Versand: €6.90

300370 16,52 mm - EKAREAM - - VHM Reibahle
€394.32
inkl. MwSt. zzgl. Versand

Aluminium-Bild gebürstet Gold Silber Kupfer ️ Tropischer Wasserfall | Querformat | wandbild.com 140 x 105
€409.00
inkl. MwSt. zzgl. Versand

normani Base Layer 'Delamere' Herren Größe 4XL schwarzmeliert
€49.95
inkl. MwSt. zzgl. Versand
Versand: €0.00
Stoßstangenecke hinten links Opel Grandland ab Bj. 2025
€246.33
inkl. MwSt. zzgl. Versand

Kohlebürsten für Makita Bohrmaschine 8410BV - 5x8x11mm
€11.95
inkl. MwSt. zzgl. Versand
Versand: €0.00

Das sich entwickelnde Verfassungsrecht der Europäischen Union
€52.84
inkl. MwSt. zzgl. Versand
Versand: €0.00

Semion Shmelkov, Akkordeon (CD)
€12.99
inkl. MwSt. zzgl. Versand
Versand: €2.99

Alu-Dibond Bild ️ Der Eisbär | Querformat | wandbild.com 200 x 150
€769.00
inkl. MwSt. zzgl. Versand
